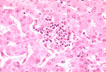

VIRAL HEPATITIS B
ETIOLOGY
THE VIRUS
The virus is a Hepadnavirus (from Hepa=liver,
dna=DNA ), a family of viruses that produce hepatitis in
woodchucks, squirrels, ducks and humans. It is responsible for the
most chronic infectious disease in the world. Around 300 million
people are infected and over 1 million die every year of cirrhosis
and liver cancer induced by this infection.
|
The hepatits B virus
|
Fig 94 - The hepatitis B virus: Partially double and
single-stranded DNA genome enclosed in a icosahedral
nucleocapsid (core antigen) of 27 nm in diameter
which is surrounded by a glycoprotein envelope of 42 nm in
diameter (surface antigen). The virus therefore,
possesses two shells. Core antigen in seen in the liver but
not in the blood. Anti core antibody is detected in the
blood. The surface antigen is produced by the virus in large
quantities and shedded in the blood stream as spherules and
rods of 22 nm diameter entirely composed of glycoproteins.
Among them, under electron microscopy are larger spherule of
42 nm diameter which are the intact virions, the Dane
particles. HE protein is present in the blood in carriers
and correlates with viremia.
|
|
Surface antigen in hepatocyte
|
Fig 95 - Surface antigen in hepatocyte: It is present as
brown granules only in the cytoplasm of hepatocyte. The
nuclei are stained blue with hematoxylin
counterstain.(Immunoperoxidase technique).
|
|
|
|
|
Core antigen in hepatocyte
|
Fig 96 - Core antigen in hepatocyte: At difference with
surface antigen It is present in the nuclei of hepatocyte.
Here the virus replicates and acquires the envelop of
surface antigen in the cytoplasm.
|
DIAGNOSIS OF HBV INFECTION
Presence of hepatitis B surface Antigen (HbsAg) in the blood
indicates infection.Surface antigen particles either in form of
spherule or rods are not infectious but they coexist with the
infective virion which are made of viral DNA, "e"
antigen, the capsid "c" (core) antigen and the external
envelop of "s" antigen which together form the 42nm Dane
particles.The number of virion may be very low as 1 particles per
ml or very high as millions of particles per ml.The consquences of
these different concentrations are obvious. In the nucleus of the
hepatocyte the virion has only the capsid of core antigen, but not in
the blood where core antigen cannot be detected.The virion has a
genome or circular DNA of 3221 bases only partly double stranded.
Most of the genomic sequence is occupied by the gene for viral DNA
polymerase which is another parameter for diagnostic assay. After
the virus has invaded the cell it induces the cell to synthesize RNA
which through viral reverse transcriptase induces the
synthesis of viral DNA which with the antigens of the core and
surface produced by the hepatocyte form the complete virion which
goes to infect another hepatocyte. The assaying of these viral
components provide the data for the assessment of the presence and
the activity of viral hepatitis B infection.
COURSE OF HB. INFECTION
The characteristic of HBV infection is that of producing a
spectrum of clinical manifestations which vary from the mildest
subclinical resolving cases to the most dramatic rapidly fatal
illnesses or the most persistent chronic infection progressively
leading to incurable complications. The course is affected by two
factors: the viral charge and the host response.
The virus may produce :
1 - An asymptomatic transient infection
- HBV-DNA is of low titre and limited in time. The virus
disappears before serum transaminases rise.
- ALT elevation is slight or moderate.
- Serum HbsAg is detectable for a few (2-3-) months and
soon will convert to antibody.
- Serum anti-HBs indicates the end of the infection and
will be present for life.
- IgM anti-HBc antibody will appear toward the end of
transaminase (ALT) elevation and will last for 2-3 months.
- IgG anti-HBc antibody together with anti surface
antibody will be present for life.
- Clinical disease is non existent.
2 - An acute resolving hepatitis
- The course of the infection is similar to the asymptomatic
transient infection with the difference that there is the
symptomatology of jaundice with marked elevation of ALT and AST
and all viral antigens ,HBs, Hbc, He HBV-DNA. At 6 months the
antigens convert to antibodies, the symptoms disappear, the
infection resolves. IgM anti-HBs persists for about a year than
IgG anti-HBs remains for life.
3 - An acute chronic hepatitis B
- Chronicity is characterized by persistence of viral
replication with attached viral antigens for over 6 months,
sometimes returning to normal in many years or advancing to induce
cirrhosis and/or hepatocellular carcinoma. The chronicity of
hepatitis B may follow either a symptomatic acute icteric
hepatitis or, more commonly, an asymptomatic silent infection.
PATHOLOGY OF ACUTE ICTERIC HEPATITIS B
|
"Lobular disarray"
|
Fig 97 - "Lobular disarray": Loss of hepatocyte,
inflammatory reaction, Kupffer cell mobilization an
hepatocellular swelling distort the pattern of the liver
plates somewhat confusing the lobular architecture.(H&E
stain).
|
|
|
|
|
Focal necrosis
|
Fig 98 - Focal necrosis: In the center of this slide there
is a focus of cell dropout with inflammatory reaction
|
|
|
|
|
Confluent necrosis
|
Fig 99 - Confluent necrosis: It is the confluence of many
groups of focal necrosis. Note multiple foci of cell
dropout. The tissue was stained with PAS technique which
stains glycogen granules red.
|
|
|
|
|
Bridging necrosis
|
Fig 100 - Bridging necrosis: It is the confluence of many
groups of focal necrosis. Note multiple foci of cell
dropout. The tissue was stained with PAS technique which
stains glycogen granules red.
|
|
|
|
|
Massive and submassive hepatic necrosis
|
Fig 101 - Massive and submassive hepatic necrosis: Massive
necrosis is fatal, involving the entire liver parenchyma.
Submassive necrosis may not be fatal involving more severely
large areas of the liver but less severely in other areas.
It is , however, complicated by cirrhosis. Here is an
example of submassive necrosis. Only a few periportal liver
cell plates are viable in this open liver biopsy but other
parts of the liver were less damaged.
|
|
|
|
|
Portal and periportal inflammation
|
Fig 102 - Portal and periportal inflammation: Portal
inflammation is always present in most portal tracts. The
inflammatory cell s are mostly lymphocytes sometimes forming
lymphoid follicles, plasma cell containing gamma globulins
mostly IgG type, macrophages containing iron granules. There
may be bile duct damage. Periportal inflammation with
disruption of periportal limiting plate and piecemeal
necrosis is also present. An acute hepatitis with portal
inflammation and many segmented leucocyte and eosinophils is
usually not viral. In this case of acute hepatitis B there
is marked portal inflammation and periportal piecemeal
necrosis with ballooned hepatocyte.
|
|
|
|
|
Hepatocellular damage
|
Fig 103 - Hepatocellular damage: Hepatocyte suffer shrinkage
with formation of acidophilic bodies (Councilman bodies),
swelling ('ballooning degeneration"), accumulate bile
pigment and drop out leaving gaps which in resolving cases
will be filled with new cells. Notice in this slide swollen
hepatocyte and two Councilman bodies.
|
|
|
|
|
Fulminant fatal acute viral hepatitis
|
Fig 104 - Fulminant fatal acute viral hepaptitis: The liver
is soft, flabby, friable, yellowish-green, collapsed,
shrunken ("acute yellow atrophy")
|
PATHOGENESIS
After infection the virus induces the hepatocyte to synthesize
non- particulate Core antigen which is transported to the nucleus and
assembled in core particles, 27nm in diameter. These particles can be
demonstrated by immunostains. Presence of Core antigen particles in
the nucleus indicates active viral replication. These particles flow
from the nucleus into the cytoplasm and into the cisternae of the
rough cytoplasmic reticulum where, with surface antigen synthesized
in the same cisternae form the complete Dane particles which are
released into the extracellular space with large amounts of excessive
surface antigen. The question to ask is : is the cellular damage a
direct effect of the virus or the result of an immune response of the
host? It appears the virus is not cytotoxic and the cytolysis is
apparently produced by cytotoxic lymphocytes sensitive to one or more
viral antigens. This theory was postulated in 1972. (Dudley,
Lancet, I: 723, 1972). In 1981 it was discovered that HBV-DNA in
hepatocyte may exist as an integrated (double-stranded, intranuclear)
form or as an episomal (free, circular, low- molecular weight,
single- stranded, intracytoplasmic ) form. Both forms may exist in
the same hepatocyte. (Shafritz, NEJM, 305:1067,1981).It
appears that active viral replication is associated with
predominantly episomal viral DNA while low replication is associated
with integrated viral DNA.Cases of chronic hepatitis of short
duration (1-2 years) exhibit predominantly episomal (cytoplasmic)
viral DNA while cases of longer (6-8 years) duration exhibit
integrated, intranuclear viral DNA. Cytotoxic T-.lymphocytes
sensitive to viral antigens mediate the lysis of infected
hepatocytes.(Thomas et al, Hepathology 2; 116S-121S, 1982).
Montano et al, Hepatology, 3:292-296,1983)
DIAGNOSIS OF ACUTE ICTERIC HEPATITIS B
|
Diagnostic features
|
Fig 105 - Diagnostic features:
The incubation period may be very long. General
symptoms arise weeks before the jaundice.Serum
transaminases are elevated even before general symptoms
and jaundice appear. Surface antigen ( HbsAg) may be
detected by radioimmunoassay as early as one week after
contacting the virus by parenteral inoculation and 3-4-5
weeks before having any feeling of being sick.
|
|
|
|
ACUTE HEPATITIS B, Clinical Forms, In Adults
- SYMPTOMLESS INFECTION: The majority of cases. The
disease goes completely unnoticed.
- ANICTERIC HEPATITIS: The infection produces a flue-like
illness without jaundice.
- ACUTE ICTERIC HEPATITIS: The patients becomes overtly
jaundiced.
- RESOLVING: It resolves in 6 months
- FULMINANT HEPATITIS: 1% of acute icteric hepatitis.
This complication is fatal
- PROLONGED: If it lasts more than 4 months.
- CHOLESTATIC FORM: Less common than in hepatitis A.
Recovery , although prolonged, is good.
- SUBACUTE HEPATIC NECROSIS: 3%. These patients will
clinically deteriorate for a period of 2-3 months and develop
deepening of jaundice, sings of portal hypertension, worsening of
coagulation factors but will not die.This course is seen in
patients over 40 years of age , patients with AIDS, drug addiction
and as development of an initial anicteric hepatitis.
- CONVALESCENCE PERIOD: May be long with malaise and
fatigue for weeks.
- RELAPSES: 1-3%. The course may be fatal especially if
it is associated with viral hepatitis D.
- CHRONIC HEPATITIS: At least 10% of all infected people,
either symptomatic or non- symptomatic.
ACUTE VIRAL HEPATITIS B, Extrahepatic manifestations
- ARTHRITIS-DERMATITIS: a serum sickness-like syndrome is
an occasional extrahepatic manifestation of acute hepatitis B.
These patients experience urticaria, rash, petechiae, palpable,
purpura, arthralgia and arthritis of small joints. It involves
mostly small joints of hands and knees and occurs in the prodrome
period, before jaundice appears and resolves within a week.
Arthritis may be accompanied by urticaria, palpable purpura,
erythema multiforme, erythema nodosum , liken planus.
- GIANOTTI SYNDROME (Infantile papular
acrodermatitis):Papular skin eruptions with generalized
lymphadenopathy in children under eight years. The hepatitis is
mild and anicteric and can be transmitted on contact to adults who
may develop an icteric hepatitis.
- NERVOUS SYSTEM: Seizures (rare), Guillain-Barre'
syndrome, peripheral neuropathy, mononeuritis multiplex.These
symptoms resolve at the end of the acute illness.
- CARDIO-VASCULAR SYSTEM: Pericarditis, myocarditis may
occur especially in the fulminant type. Polyarteritis nodosa is
seen in chronic hepatitis B.
- GASTRO-INTESTINAL TRACT: Pancreatitis.The virus
replicates in the pancreas. Pancreatitis has been observed after
liver transplantation for hepatitis B. HbsAg has been demonstrated
in the pancreas.
- URINARY SYSTEM: resolving mild renal failure may occur
in the acute phase. Membranous glomerulonephritis occurs in
chronic hepatitis B.
- HEMOPOIETIC SYSTEM: aplastic anemia
(rare).Cryoglobulinemia of mixed type can be seen in hepatitis B
infection. The serum contains cryoprecipitable IgG and IgM
proteins with anti-gamma globulin activity producing purpura,
arthritis, glomerulonephritis and generalized vasculitis
apparently due deposits of immunoglobulin-complement complexes in
the vascular wall.
(References: 1-Bader TF:Viral hepatitis, practical evaluation and treatment,
H&H Publishers 1995.
2-Seef LB: Diagnosis, therapy and prognosis of viral hepatitis
in: Zakin D, Boyer TD,eds.Hepatology: a Textbook of liver
disease. Wb Sanders, Philadelphia, 1990.
3-Dusheiko G, Hoofnagel JH in: Oxford textbook of clinical
hepatology; Oxford University Press 1991, Mc Intire N,Benhamou
JP,Bircher J,Rizzetto M,Rodes J, Editors.
CHRONIC HEPATITIS B
DEFINITION: PERSISTENCE OF HEPATITIS B VIRUS FOR MORE THAN
6 MONTHS.
The persistence of the virus produces different damage in
different individuals depending on the viral charge and the host
reaction.The majority of patients, 3/4, a mild or minimal or no
damage at all. They look " healthy" and almost all become free of
disease. These are asymptomatic carriers. A smaller number of
patients, 1/4, have more damage,are "sick" an d most of them develop
complications, namely, cirrhosis and hepatoccellular carcinoma.These
are the symptomatic carriers.All chronically infected patients ,
however, either healthy looking or sick, can transmit the virus on
contact.
PATHOLOGY OF CHRONIC HEPATITS B
In chronic hepatitis histological examination of the liver is
nacecessary in order to eastimate the the presence , activity, and
extent of the liver damage,detect stigmata of different viruses,
supply creteria for treatment, evaluate results of treatment and
detect complications (fibrosis, cirrhosis, hepatocellular carcinoma).
In order to standardize the language of their reports, a group of 9
pathologists in 1968 proposed the following reporting format.
- CHRONIC PERSISTENT (CPH) for "healthy" carriers.
- CHRONIC ACTIVE (CAH), for sick carriers.
- CHRONIC LOBULAR (CLH), for sick carriers with good
prognosis which appear to represent"acute prolonged" cases.
(Lancet 1968;ii:626-628).
Due to the simplicity of this subdivision , the advent of
treatment with interferon and the necessity to estimate more
adequately the results of the treatment another group of 16
pathologists in 1995 devised a numerical system to report the
grade and the stage of the lesion.(Journal of
Hepatology 1995;22:696-699). Grade is the intensity of
necrosis and inflammatory reaction. Stage is the structural
progression of the disease. The following scoring scheme has been
proposed.
TABLE 1 - GRADING: Necroinflammatory scores Score
A. Periportal or periseptal interface hepatitis
(piecemeal necrosis)
Absent 0
Mild (focal, few portal areas) 1
Mild/moderate(focal, most portal areas) 2
Modearte(continuous around 50% of tracts or septa) 3
Severe(continuous >50% of tracts or septa 4
B. Confluent necrosis
Absent 0
Focal confluent necrosis 1
Zone 3 necrosis in some areas 2
Zone 3 necrosis in most areas 3
Zone 3 necrosis + occasional portal-central (P-C) bridging 4
Zone 3 necrosis + multiple P-C bridging 5
Panacinar or multiacinar necrosis 6
C. Focal (spotty) lytic necrosis, apoptosis and focal
inflammation
Absent 0
One focus or less per 10X objective 1
Two to four foci per 10X objective 2
Five to ten foci per 10X objective 3
More than ten foci per 10X objective 4
D. Portal inflammation
None 0
Mild, some or all portal areas 1
Moderate, some or all portal areas 2
Moderate/marked, all portal areas 3
Marked, all portal areas 4
Maximum possible score for grading = 18
Additional features (not to be scored):
Bile duct inflammation and damage
Lymphoid follicles
Steatosis, mild, moderate, marked
Hepatocellular dysplasia, large or small cell
Adenomatous hyperplasia
Iron or copper overload
Intracellular inclusions (PAS-positive globules, Mallory bodies)
Immunohistochemical findings (not to be scored):
Viral antigens, lymphocyte subsets
TABLE2 - STAGING: Architectural changes, fibrosis and cirrhosis Score
No fibrosis 0
Fibrous expansion of some portal areas with or without 1
short fibrous septa
Fibrous expansion of most portal areas with or without 2
short fibrous septa
Fibrous expansion of most portal areas with occasional 3
portal-portal bridging
Fibrous expansion of portal areas with marked portal-portal 4
(P-P) and portal-central (P-C) bridging
Marked bridging (P-P and/or P-C) with occasional nodules 5
(incomplete cirrhosis)
Cirrhosis, probable or definite 6
Maximum possible score 6
Additional features (not to be scored):
Intra-acinar fibrosis. Perivenular ("chicken-wire")fibrosis.
Phlebosclerosis of terminal hepatic venules.
The report may include the numerical score, especially in evaluating the
effect of treatment, and always resumptive wards. The following
categories are easily separated.
1-Asymptomatic carrier state
2-Minimal chronic hepatitis
3-Mild " "
4-Moderate " "
5-Severe chronic hepatitis with/without cirrhosis.
The same type of grading and staging is used for chronic hepatitis due to
other causes such as chemicals and immunological etiologies.
The final management of each case, besides the histological changes will
take into consideration also laboratory findings, clinical symptoms and
viral charge.
ASYMPTOMATIC CARRIER STATE
Are those individuals who are healthy, histologically do not show
any liver damage except ground glass hepatocyte which are loaded with
hepatitis B surface antigen but they ar infected with the hepatitis B
virus.
|
Ground-glass hepatocytes
|
Fig 106 - Ground-glass hepatocytes
|
|
|
|
Example of minimal or mild chronic hepatitis B
(CHRONIC PERSISTENT HEPATITIS (CPH)
Three-fourths of patients chronically infected with hepatitis B
virus will have the mild forms of chronic hepatitis with: no, minimal
or mild histological changes.-Minimal or no elevation of
transaminases (ALT,AST). B viral DNA will be present.
EXAMPLE
44 year old male, 10 years after hepatitis B infection. ALT 117,
AST 66, Alkalin Phosphatase 160.
|
|
Fig 107 - Moderate Inflammation of occasional portal tracts. Notice
one inflammed portal area and tow others
relatively normal.
Also there is no significant necroinflammatory
necrosis of
the lobular parenchyma
|
|
|
|
|
|
Fig 108 - In the inflammed portal field there is minimal erosion of
the limiting plate and little interface
(piecemeal )
necrosis.
|
|
|
|
|
|
Fig 109 - The non-inflammed portal field is somewhat expanded with
fibrosis but has intact limiting plate.There is
no
periportal fibrosis.
|
|
|
|
|
|
Fig 110 - Very occasional apoptotic cells (Councilman bodies) are seen in the lobular parenchyma.
|
|
|
|
Interface hepatitis = 1
Interface hepatitis = 1
Confluent necrosis = 0
Focal necrosis = 1
Portal inflammation = 2
Fibrosis = 1
Total score= 5 (range 1-24)
Example of Severe Chronic Hepatitis B wthout Cirrhosis.
(Chronic active hepatitis, severe)
Example with Total score = 13 (range 1-24).
|
|
Fig 111 - Marked Inflammation of all portal fields. Notice three portal fields infiltrated by inflammatory cells
with erosion of limiting plates. Score=4
|
|
|
|
|
Interface hepatitis
|
Fig 112 - Interface hepatitis: Marked mononuclear
infiltration of all portal tracts with erosion
of limiting
plates and piecemeal necrosis. Score=4
|
|
|
|
|
Lobular inflammation
|
Fig 113 - Lobular inflammation: There is no confluent
necrosis but there is focal necrosis with
Councilman bodies,
one with a pyknotic nucleus. Score=2
|
|
|
|
|
Fibrous changes
|
Fig 114 - Fibrous changes: Fibrous expansion of all portal
fields with occasional portal-portal Bridging.
Score=3
|
|
|
|
COURSE OF CHRONIC HEPATITIS B
Course in adults
- 1/4 circa of acutely infected patients will develop a chronic
course.
- 80-85% of chronic carriers will have complete resolution.
- 15-20% of chronic carriers will develop complications.
Remission can occur after years or decades of persistent illness
and is indicated by the disappearance of viral DNA,DNA polymerase
activity, HBeAg and normalization of serum transaminases. Some (10%)
of patients may have the reactivation of the process more than once
in a progressively aggressive manner and die of cirrhosis.
Course in children
The infection of hepatitis B in children has a different course.
- Children are more easily infected than adults by playing with
other children.
- 90% of infected children will develop a chronic course. More
than adults.
- The majority of infected children are asymptomatic.The younger
the child, the more asymptomatic.
- Children however , either symptomatic or asymptomatic, grow
normally.
- Chronic hepatitis seldom progresses to cirrhosis. If it does
superinfection with hepatitis D or C must be suspected.
- Also hepatocellular carcinoma is extremely rare but it may
occur.
- The disappearance of HBe Ag and viral DNA during childhood
indicates the end of viral replication.
- Surface antigen however persists after childhood and clears up
in 10-20 years.
- Histology shows minimal or no damage.
- Carrier children should not be treated with alpha-interferon.
COMPLICATIONS
The disease becomes life-threatening only when cirrhosis and/or
hepatocellular carcinima develop.The following complications are
encountered:
1-RECURRENT FLAR-UPS.They are common in chronic hepatitis
and each time they cause more scarring.
2-CIRRHOSIS, slow progressing.It develops in a small
percentage of patients and early in the fist few years of the
disease. Alcohol even in small amounts will adversely affect the
course of the cirrhosis.
3-HEPATOCELLULAR CARCINOMA. It may arise with presence or
even absence of cirrhosis.In the Orient the incidence of carcinoma is
15% with men more affected than whomen.The incidence is less in the
western world.
4- IMMUNE COMPLEX DISEASE, (polyarteritis nodosa,
membranous glomerulonephritis).
- Polyarteritis nodosa (HBV-PAN) is a rare complication,
however a large number of patients with PAN (up to 80%) have
evidence for hepatitis B infection. (Silva AEB et al.
Hepathology16: 16-65, 1992). The arteries have immune complexes of
surface antigen and surface antibodies. Mortality rate in 3 years
is very high (40%). Treatment with plasmapheresis and adenosine
arabinoside is at present the only one recommendable.
- Glomerulonephritis (HBV-GN). It is extremely rare in
chronic carriers, however evidence of HBV infection is very
frequent (11-56%) in glomerulonephritis.(Bodsworth N, et al.J.
Infect Dis. 163: 1138-1140,1991). The most common form of
nephritis is membranous glomerulopathy. There is spontaneous
remission in 1/3 of the children. No spontaneous remission in
adults. Remissions in adults have been obtained with
alpha-interferon.
PROGNOSTIC FACTORS FOR CHRONIC HEPATITIS B
Incidence of chronicity of viral hepatitis B as well as its course
and outcome is very variable and is influenced by several factors:
AGE: It is here opportune to remember that only 5-10 % of
adults infected with hepatitis B virus will become chronic carriers
while the infection in I children will become chronic in up to 90 %
of infections contracted in the perinatal period and in a lower
percentage in children with more advanced age. While, however, 20% of
adults wit chronic disease develop cirrhosis, children do not and
progressively, in years , they clear the virus.
SEX: It appears that males are more affected than females.
FORM OF ACUTE INFECTION: The patients with mild and
asymptomatic infection are more prone to become chronic than patients
with acute icteric disease. The acute icteric infection has better
tendency to resolve than occult infections
VIRAL REPLICATION:
HIGH, high viral DNA , HBsAg+, HBeAg+
It has the highest probability to develop cirrhosis and
hepatocellular carcinoma and a small probability to seroconvert to
negative" e" antigen and heal in 1-20 years.
LOW, low viral DNA , Hbs Ag+, HBeAg -, Anti HE +
It does not produce cirrhosis but may generate hepatocellular
carcinoma.
Healing from this form occurs at the rate of 1-2% per year and is
indicated by the appearance of Anti-HE antibodies.
NONE, Absence of viral DNA, HbsAg -,Anti-HBsAg+,HBeAg-,Anti-HBeAg+.
The liver is normal.
HISTOLOGY:
CERTAINLY PROGRESSIVE: Severe chronic changes with bridging necrosis and
with HBV-DNA and positive HbeAg will certainly lead to cirrhosis.
POSSIBLY PROGRESSIVE: Chronic active changes more than mild changes
with HBV-DNA+ or HbeAg+ may lead to cirrhosis.
NON-PROGRESSIVE: Chronic active changes (CAH) less than chronic
persistent changes (CPH) without HBV-DNA or HbeAg
may not lead to cirrhosis.
Histology alone cannot predict the evolution of the infection.
HOST RESPONSE:
GROUP I: Asymptomatic with normal ALT , negative HbeAg.
GROUP II: Elevated ALT, negative HBV-DNA, no cirrhosis.
GROUP III: Cirrhotic patient.
EPIDEMIOLOGY AND PREVENTION OF VIRAL HEPATITIS B
The infection is acquired from blood and secretios of infected
individuals.The disease is not highly infectious. The carriers with
viral replication activity which is indicated by HbeAg and HBV-DNA
are the most dangerous. Almost one half billion people throughout the
world are infected by this virus.Its mortality is higher than AIDS
over which the HBV infection has the advantage of an effective and
safe vaccine and , therefore, it can be prevebted.The vaccines
presently used are composed of viral surface antigen (Hbs Ag)
obtained from the common baker's yeast,Saccharomyces cerevisiae, by
inserting into it a gene for the synthesis of HbsAg.These are
Yeast-Recombinant vaccines.Before this technology was devised,
vaccines were made with Hbs Ag extracted from the plasma of infected
patients with a high level of surface antigen.An hepatitis B
Immunoglobulin (HBIG) is also available.It is prepared from plasma
with a high titre of anti surface antibody(anti-Hbs Ab).It is
administered to adults who have become in blood contact with an
infected person and to children born to HBsAg positive mothers.The
combination does not inactivate the immune response to yeast
recombinant vaccine which can be administered even during
pregnancy.Obviousely the vaccination is performed after testing for
naturally existing immunity for HBV infection. Anti-HBc will identify
immune individuals and chronic carriers. Anti-HBs will identify only
immune individuals.The following individuals should be vaccinated:
Household contacts, sexual contacts, medical care workers,
hemodialysis patients, patients with repeated transfusion of blood
and blood products, HIV positive individuals, intravenous drug
abusers, contact with endemic areas.The vaccine is most effective
when given in the deltoid muscle.90% of recipients responde.The
immune antibody after vaccination is detectable up to 10 years but
immunity appears to be longer. Rivaccination is so far not
conteplated.
Treatment of viral hepatitis B
Drug treatment consists of alpha-interferon injections 3 times a
week for 3-4 months under medical monitoring for side effects which
are flue-like illnesses and changes in blood counts It is effective
in 30-50 % of patients. In some cases the treatment may worsen the
hepatitis. At difference of hepatitis C where interferon lessens the
hepatitis. While C virus is a cytopathic virus and produces direct
injury to the hepatocyte, B virus produces injury through an
immune reaction mechanism the lymphocytes of the host which
have become sensitive to the viral antigens such as surface antigen
produce the necrosis of hepatocyte.Alpha- interferon in hepatic C
causes inhibition of virus C and therefore causes less cell necrosis
and a decrease of (ALT). Interferon in hepatitis B induces
disappearance of the virus which increases lymphocyticsensitization
to viral products and consequent more hepatocytic necrosis.The
hepatitis will flare-up and serum transaminases will rise more than 2
folds with the possibility of death.Response to treatment in
hepatitis B is slower than in hepatitis were it can be observed in a
couple of weeks. The suppression of the virus is indicated by the
disappearance of the viral replication markers: Hbe Ag and HBV-DNA.
HBsAg may remain for longer time.Interferon treatment does not work
well in patients
- who are not very sick
- who have impaired immune system such as in AIDS.
- children who contracted the infection from their mothers at
birth.
Transplantation is the other treatment for actively replicating
viral hepatitis BOTH. infection will recur in almost in every new
graft sometimes with a serious type of cholestatic hepatitis,
Fibrosing cholestatic hepatitis.(Davies et al, Hepatology,
13:150-157, 1991).Rapidly advancing cirrhosis and hepatocarcinoma
are more frequent.The one year survival is 60% and 5 year survival is
50%.(Starzl et al,New Eng. J. Of
Med.321:1092-199,1989).Transplantation is a preferable approach
in acute fulminant viral hepatitis B.In order to prevent a certain
infection of the graft the operation is done with large doses of
hepatitis B immune globulin (HBIG).
CONTENTS